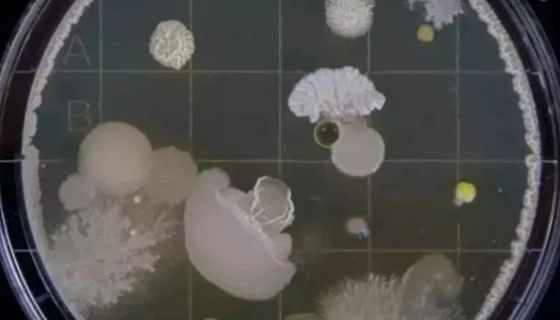
ATCC 33173 伸长盐单胞菌 百欧博伟生物
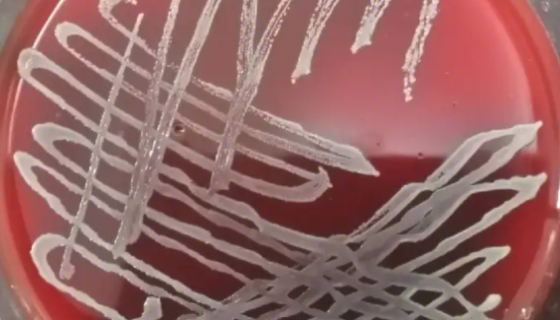
魏氏柠檬酸杆菌的培养方法与注意事项及打管说明！
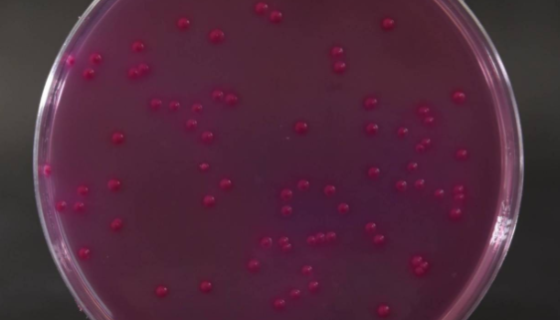
结晶紫中性红胆盐琼脂的制备方法！

克鲁斯假丝酵母的培养方法与注意事项及打管说明!
克鲁斯假丝酵母是Candida属的微生物,原产地为中国。属于...

人皮肤鳞癌细胞的传代与冻存方法及其应用!
人皮肤鳞癌细胞源自一位患有皮肤鳞状细胞癌的85岁女性,是Gi...

粉状毕赤酵母——用于教学与研究及白酒的生产
粉状毕赤酵母是Pichia属的微生物,原产地为中国。主要用途...

格氏乳球菌的培养方法与实验内容及使用范围!
格氏乳球菌是Lactococcus属的微生物,原产地为中国。...

ATCC 29696 溶血性曼氏杆菌的特性与培养!
溶血性曼氏杆菌是Mannheimia属的微生物,原产地为中国...
ATCC 33173 伸长盐单胞菌 百欧博伟生物
伸长盐单胞菌是Halomonas属的微生物,原产地为德国。模...
魏氏柠檬酸杆菌的培养方法与注意事项及打管说明!
魏氏柠檬酸杆菌是Citrobacter属的微生物,原产地为美...

MH3924A大鼠肝癌细胞复苏与传代及冻存操作步骤!
大鼠肝癌细胞MH3924A取自ACI大鼠。仅用于科学研究或者...
结晶紫中性红胆盐琼脂的制备方法!
结晶紫中性红胆盐琼脂用于大肠菌群的固体平板检测。